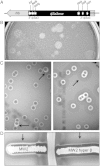

Staphylococcus aureus β-toxin production is common in strains with the β-toxin gene inactivated by bacteriophage
- PMID: 24620023
- PMCID: PMC4202305
- DOI: 10.1093/infdis/jiu146
Staphylococcus aureus β-toxin production is common in strains with the β-toxin gene inactivated by bacteriophage
Abstract
Background: Staphylococcus aureus causes life-threatening infections, including infective endocarditis, sepsis, and pneumonia. β-toxin is a sphingomyelinase encoded for by virtually all S. aureus strains and exhibits human immune cell cytotoxicity. The toxin enhances S. aureus phenol-soluble modulin activity, and its activity is enhanced by superantigens. The bacteriophage φSa3 inserts into the β-toxin gene in human strains, inactivating it in the majority of S. aureus clonal groups. Hence, most strains are reported not to secrete β-toxin.
Methods: This dynamic was investigated by examining β-toxin production by multiple clonal groups of S. aureus, both in vitro and in vivo during infections in rabbit models of infective endocarditis, sepsis, and pneumonia.
Results: β-toxin phenotypic variants are common among strains containing φSa3. In vivo, φSa3 is differentially induced in heart vegetations, kidney abscesses, and ischemic liver compared to spleen and blood, and in vitro growth in liquid culture. Furthermore, in pneumonia, wild-type β-toxin production leads to development of large caseous lesions, and in infective endocarditis, increases the size of pathognomonic vegetations.
Conclusions: This study demonstrates the dynamic interaction between S. aureus and the infected host, where φSa3 serves as a regulator of virulence gene expression, and increased fitness and virulence in new environments.
Keywords: Staphylococcus aureus; bacteriophage; infective endocarditis; pneumonia; sepsis; β-toxin.
© The Author 2014. Published by Oxford University Press on behalf of the Infectious Diseases Society of America. All rights reserved. For Permissions, please e-mail: journals.permissions@oup.com.
Figures

Comment in
-
Reply to Dupieux et al.J Infect Dis. 2015 Mar 1;211(5):847-8. doi: 10.1093/infdis/jiu495. Epub 2014 Sep 1. J Infect Dis. 2015. PMID: 25180237 No abstract available.
-
Does β-toxin production contribute to the cytotoxicity of hypervirulent Staphylococcus aureus?J Infect Dis. 2015 Mar 1;211(5):846-7. doi: 10.1093/infdis/jiu494. Epub 2014 Sep 1. J Infect Dis. 2015. PMID: 25180238 Free PMC article. No abstract available.
References
-
- Klevens RM, Morrison MA, Nadle J, et al. Invasive methicillin-resistant Staphylococcus aureus infections in the United States. JAMA. 2007;298:1763–71. - PubMed
-
- Fowler VG, Jr., Miro JM, Hoen B, et al. Staphylococcus aureus endocarditis: a consequence of medical progress. JAMA. 2005;293:3012–21. - PubMed
-
- Shorr AF, Tabak YP, Killian AD, et al. Healthcare-associated bloodstream infection: a distinct entity? Insights from a large US database. Crit Care Med. 2006;34:2588–95. - PubMed
Publication types
MeSH terms
Substances
Grants and funding
LinkOut - more resources
Full Text Sources
Other Literature Sources
Molecular Biology Databases